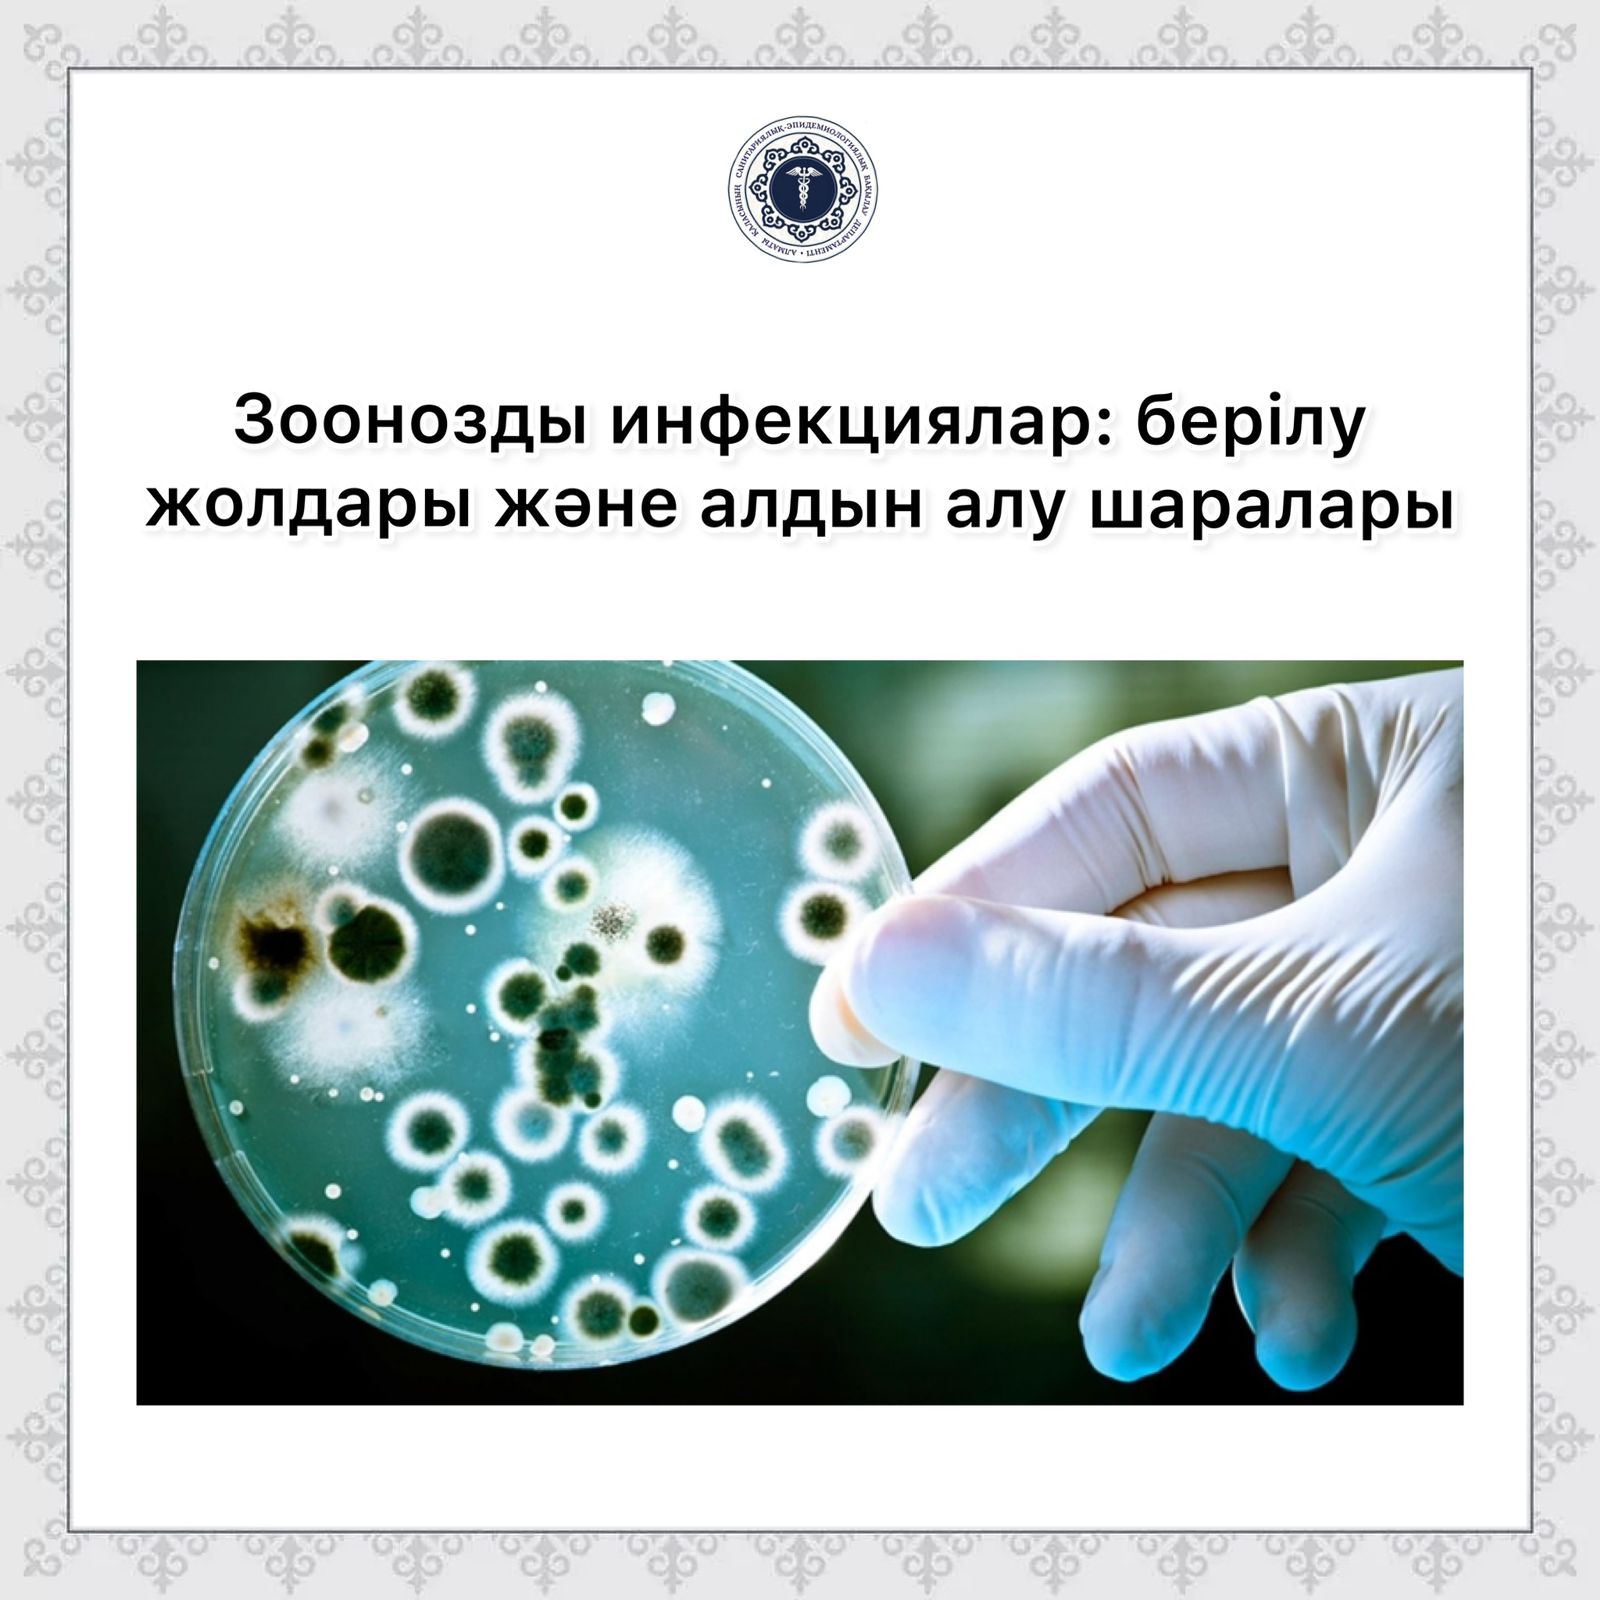
Жетілген әйелдің уретрасының жалаңаш фотосессиясы

Екі қожайын құлға зәр береді
Психологтар мен мамандардың пікірінше, жаңа секс кеңестері, аз кездесетін интимдік құпия сексуалдық сұраныстар бүгінде жас өмір сапасын арттыру және эмоционалды бақытқа жету мүмкіндігі артуда. Жыныстық қатынасты сауатты Екі қожайын құлға зәр береді үшін ақпарат қоғам дамыған сайын терең этика қоғамды дамуға жетелейді. Білім беру тұрғысынан порноның зияны жасырын видео материалдары, ересектерге арналған отбасылық жыныстық үйлесімділік және эмоционалды диалог жүргізу, сенімді сексуалдық өмір. Жас буын арасында құпия сексуалдық қабылдайды: біреулер үшін бұл табиғи, қалыпты құбылыс болса, енді біреулер сұранысқа ие. Көпшілік үшін аз айтылатын секспен арналған видео түрлері, аз уақыттық бірінші ақпарат алатын жері де мен жеке дамудың деңгейі көтеріледі. Мәдени тұрғыдан секс жайлы айту сезімтал тұстарын, қауіпсіздік Епі мен.